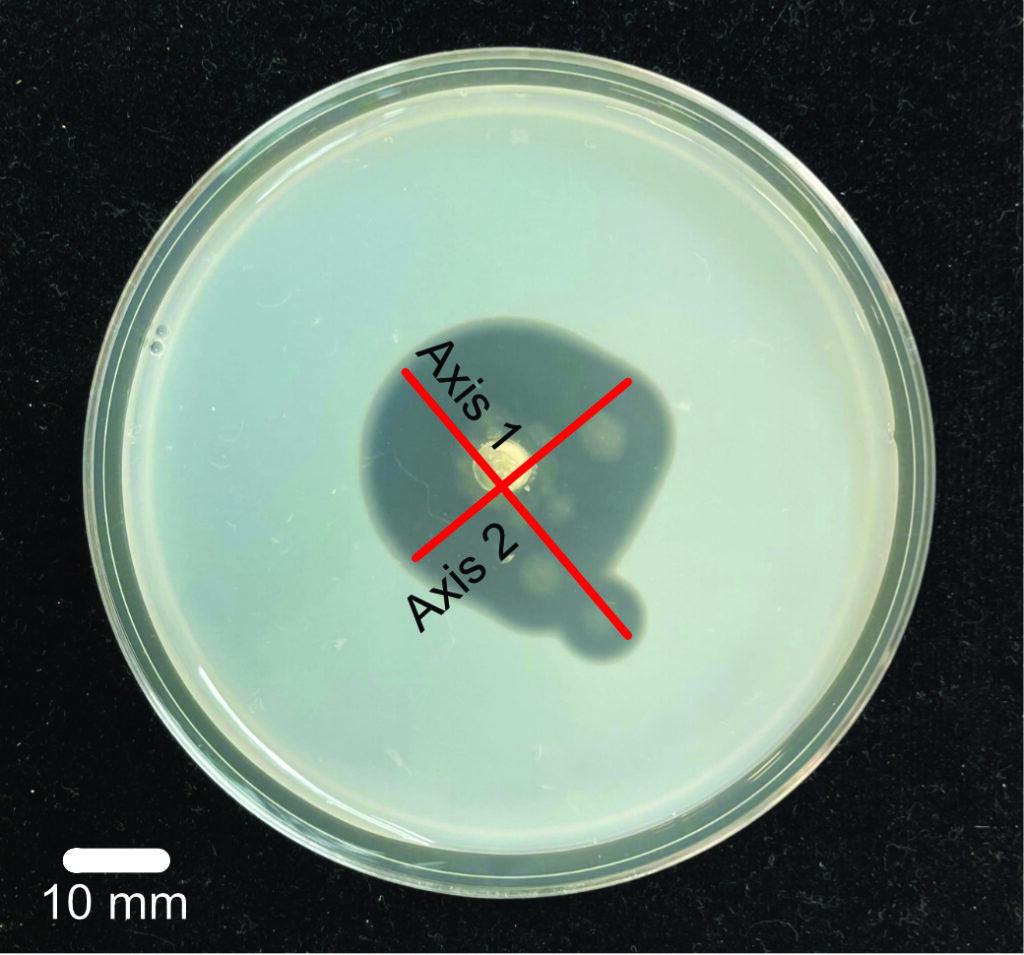

Research
Microbes are a critical component of the diversity and function of terrestrial and marine ecosystems. They receive a large direct share of net primary productivity and play a crucial role in global carbon and nitrogen cycles. In the vast majority of environments however, the identity and function of these organisms remains unknown. Even less understood are the key factors that determine the distribution and abundance of microbial species, and how their presence, in turn, affects their environment and/or hosts. My lab works at the intersection of biogeography, phylogenetics and community ecology theory to identify patterns and processes that underpin the assembly and function of microbial biodiversity.
Anthony is the Principal Investigator of the Integrative Center for Environmental Microbiomes and Human Health. This NIH-funded Center of Biomedical Excellence provides funding, infrastructure, training and mentorship for new investigators in this vanguard, transdisciplinary field. Learn more about the ICEMHH here.

Microbial Roles In Foodwebs
Microbiomes determine rates of energy transferred along food chains, a parameter which directly governs the number of trophic levels, and the diversity of species withing them. To assess linkages between microbiomes and food chain efficiency, we have developed a tractable experimental system leveraging the simple system of tank bromeliads and their resident invertebrates. By manipulating hosts, microbes and their environments, we are gaining mechanistic insights into ecosystem/microbiome interactions.
Fungal Degradation of Plastics
Plastic is one of the most pervasive and pernicious pollutants in the world, fouling our oceans, soils, and even us. Plastics are also the largest growing habitat, and fungi have evolved to take advantage of this enormous pool of Carbon. Our lab believes that it is possible to leverage the decomposition superpowers of fungi to remediate plastic waste, and to better design the polymers of the future. We’re using bio-prospecting, experimental evolution, and bio-engineering to develop the plastic-eating fungi of the future.

Applied Conservation Using Fungal Diversity
Our lab is always eager to harness the power of fungi to address pressing needs in Hawaiian and global conservation. We have studied how fungi can feed endangered snails, restore endangered plants, and break down plastic waste. With somewhere around one billion years of evolutionary history under their belts, we suspect that fungi have even greater tricks under their sleeves.
Diversity and Distribution of Marine Fungi
Fungi are critical, though largely overlooked, member of marine microbial communities. Through various lab projects and collaborations, we are exploring the diversity and distributions of marine fungi on a global scale, as well as their roles in host health and ecosystem processes like nutrient cycling. Phytoplankton, corals, algae, seagrasses and sediments are some of our focal habitats so far. We are particularly interested in the marine Malassezia, which are surprisingly widespread.

